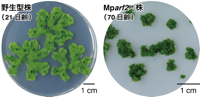

以下の69大学・研究機関の研究成果を毎日調査し、速報しています。
白抜き表示は本日の会員向け「知尋」掲載19校。掲載記事数37本。うち黒白抜き表示は本日の公開記事掲載校。
白抜き表示は本日の会員向け「知尋」掲載19校。掲載記事数37本。うち黒白抜き表示は本日の公開記事掲載校。
調査対象大学: 北海道大学、室蘭工業大学、帯広畜産大学、弘前大学、東北大学、山形大学、筑波大学、宇都宮大学、群馬大学、埼玉大学、千葉大学、
東京大学、東京科学大学、お茶の水女子大学、東京農工大学、電気通信大学、一橋大学、横浜国立大学、新潟大学、金沢大学、
北陸先端科学技術大学院大学、福井大学、信州大学、岐阜大学、静岡大学、名古屋大学、名古屋工業大学、豊橋技術科学大学、三重大学、京都大学、
京都工芸繊維大学、大阪大学、神戸大学、奈良女子大学、和歌山大学、島根大学、岡山大学、広島大学、山口大学、徳島大学、香川大学、愛媛大学、
高知大学、九州工業大学、九州大学、佐賀大学、熊本大学、鹿児島大学、琉球大学、札幌医科大学、福島県立医科大学、会津大学、東京都立大学、
横浜市立大学、岐阜薬科大学、京都府立医科大学、大阪公立大学、奈良県立医科大学、慶應義塾大学、早稲田大学、科学技術振興機構、
産業技術総合研究所、理化学研究所、物質・材料研究機構、国立がん研究センター、自然科学研究機構、高エネルギー加速器研究機構、海洋研究開発機構、宇宙航空研究開発機構
東京大学、東京科学大学、お茶の水女子大学、東京農工大学、電気通信大学、一橋大学、横浜国立大学、新潟大学、金沢大学、
北陸先端科学技術大学院大学、福井大学、信州大学、岐阜大学、静岡大学、名古屋大学、名古屋工業大学、豊橋技術科学大学、三重大学、京都大学、
京都工芸繊維大学、大阪大学、神戸大学、奈良女子大学、和歌山大学、島根大学、岡山大学、広島大学、山口大学、徳島大学、香川大学、愛媛大学、
高知大学、九州工業大学、九州大学、佐賀大学、熊本大学、鹿児島大学、琉球大学、札幌医科大学、福島県立医科大学、会津大学、東京都立大学、
横浜市立大学、岐阜薬科大学、京都府立医科大学、大阪公立大学、奈良県立医科大学、慶應義塾大学、早稲田大学、科学技術振興機構、
産業技術総合研究所、理化学研究所、物質・材料研究機構、国立がん研究センター、自然科学研究機構、高エネルギー加速器研究機構、海洋研究開発機構、宇宙航空研究開発機構
医歯薬学
東京科学大学
脳腫瘍にピンポイントで治療用ウイルスベクターを届けるナノマシン
投与量の削減により有効性と安全性の高いがん遺伝子治療を実現
![]() | AAVを用いた効率的かつ安全ながん遺伝子治療のための新しいアプローチとして臨床応用が期待 |
東京科学大学(Science Tokyo)総合研究院 化学生命科学研究所の松平望(当時 大学院博士課程学生)、本田雄士助教(川崎市産業振興財団ナノ医療イノベーションセンター主任研究員兼任)、西山伸宏教授(同主幹研究員兼任)、iCONM 喜納宏昭博士(同主幹研究員)、東京大学医科学研究所遺伝子・細胞治療センター 分子遺伝医学分野の喜納(早下)裕美特任助教、岡田尚巳教授らのグループが共同で、脳腫瘍にピンポイントでアデノ随伴ウイルスベクター(AAV)を送達する標的型ナノマシンを開発しました。この標的型ナノマシンは、がん細胞特異的に結合するタグ(荷札)分子、ワインなどの渋み成分であるタンニン酸、そして精密合成高分子から構成されています。これにより、生体内での中和抗体や免疫反応からAAVを保護しつつがん細胞まで選択的に送達し、AAV 自体の高い活性を維持したまま、がん細胞内でのみAAVを放出することが可能となります。
AAVは、遺伝子治療用ベクターとして臨床応用され近年期待が高まっていますが、がん治療においては、患部への不十分な集積と高容量投与による深刻な肝毒性が課題となります。今回、新たに開発した標的型ナノマシンを用いて、AAVを脳腫瘍へ選択的に届けることに脳腫瘍モデルマウスで成功し、従来の3分の1の投与量で高い安全性と有効性を実証することができました。
本研究成果は、これまで治療の選択肢が限られていた悪性の脳腫瘍に対して、AAVベクターを利用した遺伝子治療という新たな治療アプローチを提案し、今後の臨床応用が期待されます。
本研究成果は2025年11月29日(米国東部時間)「Journal of Controlled Release」誌にオンライン掲載されました。
関連分野複合領域 環境学 数物系科学 化学 工学 総合生物 農学AAVは、遺伝子治療用ベクターとして臨床応用され近年期待が高まっていますが、がん治療においては、患部への不十分な集積と高容量投与による深刻な肝毒性が課題となります。今回、新たに開発した標的型ナノマシンを用いて、AAVを脳腫瘍へ選択的に届けることに脳腫瘍モデルマウスで成功し、従来の3分の1の投与量で高い安全性と有効性を実証することができました。
本研究成果は、これまで治療の選択肢が限られていた悪性の脳腫瘍に対して、AAVベクターを利用した遺伝子治療という新たな治療アプローチを提案し、今後の臨床応用が期待されます。
本研究成果は2025年11月29日(米国東部時間)「Journal of Controlled Release」誌にオンライン掲載されました。
研究キーワード
創造性/産学連携/地域経済/データ解析/エステル/ボロン酸/高分子/キャリア/ポリエチレン/選択性/地域産業/地域資源/ナノ粒子/ポリエチレングリコール(PEG)/生体内/筋ジストロフィー/疎水性相互作用/エチレン/ポリフェノール/フェノール/薬剤送達システム/新規治療法/AAV/アデノ随伴ウイルス/アデノ随伴ウイルスベクター/がん遺伝子/ナノマシン/ナノメディシン/ベクター/悪性度/動物モデル/臨床応用/膠芽腫/筋萎縮/AAVベクター/モデルマウス/DDS/RNA/イミン/ウイルスベクター/がん細胞/がん治療/マウス/遺伝子治療/遺伝子導入/環状ペプチド/細胞治療/腎臓/生体分子/副作用/ウイルス/異分野融合/遺伝子/遺伝子発現/抗体/生体材料/動物実験/脳腫瘍/薬物動態
この記事の詳細を読む
![]() | 工学
東北大学
ダイナミックレンジ120dBと光量適応信号選択機能を有する3次元積層型CMOSイメージセンサを開発
―機械の「目」の高性能化・低消費電力化に貢献―
CMOSイメージセンサは車載やマシンビジョン分野のセンシング用途において、機械の「目」としての役割を持ち、さらなる高性能化への要求は高まり続けています。東北大学大学院工学研究科電子工学専攻の瀧澤康平大学院生と未来科学技術共同研究センター・大学院工学研究科の黒田理人教授らの研究チームは、露光期間中にフォトダイオード(PD)から溢れた光電荷を蓄積する横型オーバーフロー蓄積容量(LOFIC)を、画素毎に2段設けてダイナミックレンジを拡大するとともに、光量に応じて適切な信号を読み出す光量適応信号選択機能を実現しました。さらにイメージセンサチップに3次元積層技術を適用し、前例のない単位面積当...
関連分野情報学数物系科学生物学工学研究キーワード 低消費電力化/フォトダイオード/トレードオフ/CMOS/持続可能/持続可能な開発/光電変換/センシング/低消費電力
この記事の詳細を読む
|
![]() | 工学
東北大学
6兆画素/秒の読み出し速度のバースト型CMOSイメージセンサの開発
―高速度ビデオカメラシステムとして実用化に成功―
超高速イメージング技術は、衝撃波、絶縁破壊、プラズマといった極めて高速な現象を解明するために不可欠であり、イメージセンサのさらなる性能向上が期待されています。東北大学未来科学技術共同研究センター 黒田理人教授らの研究チームは、6兆画素/秒の読み出し速度を有するグローバルシャッタ方式のバースト型CMOSイメージセンサを開発しました。本センサは、2,000万コマ/秒のフレームレート・30万画素・256コマ連続記録、−170 dBの寄生光感度を同時に実現したものです。本成果は、既に高速度ビデオカメラシステム(HyperVision™ HPV™-X3)として実用化されており、幅広...
関連分野数物系科学工学研究キーワード 衝撃波/CMOS/メモリ/持続可能/持続可能な開発/超高速イメージング
この記事の詳細を読む
|
![]() | 工学
横浜市立大学
データサイエンス研究科 佐藤彰洋教授が主導して開発をすすめたメッシュ統計の国際規格(ISO 24108-1)が発行されました
日本で開発したメッシュ統計の規格が世界で初めて国際規格として発行されました
横浜市立大学大学院データサイエンス研究科の佐藤彰洋教授がプロジェクトリーダーとして日本産業標準調査会(JISC)提案として開発をすすめてきた、メッシュ統計*1の国際規格ISO 24108-1 Grid square statistics and their app...
関連分野情報学複合領域数物系科学工学医歯薬学研究キーワード 位置情報/情報システム/匿名性/空間統計/Grid/選択性/持続可能/Web-地理情報システム(GIS)/空間情報/持続可能な開発/持続可能性/公的統計/標準化
この記事の詳細を読む
|
![]() | 医歯薬学
千葉大学
ミリスチン酸のヒト食後血糖値上昇に対する抑制効果を初実証
千葉大学大学院理学研究院の坂根郁夫特任教授らの研究チームは、株式会社J-オイルミルズ、株式会社ラフィーネインターナショナル、島根大学と共同で、ミリスチン酸注1)(飽和脂肪酸注2)の一種)がヒト食後血糖値にどのような影響を及ぼすかを解析するため臨床試験を行いました。その結果、ミリスチン酸は、ヒト食後血糖値上昇に対して顕著な抑制効果があることがわかりました。 これまで飽和脂肪酸は悪玉で、その過剰摂取は避けるべきとされていましたが、飽和脂肪酸の一種であるミリスチン酸は、少量であればヒト食後血糖値の低下という善玉効果があることが、今回の研究結果により...
関連分野複合領域工学農学医歯薬学研究キーワード 産学連携/カルボン酸/炭化水素/脂肪酸/臨床試験/コレステロール
この記事の詳細を読む
|
![]() | 医歯薬学
山口大学
植物の乾燥防御の鍵:気孔閉鎖シグナル伝達を担う新規因子MAP4K1/2を発見
~長年未解明であったカルシウム制御の謎に迫る~
山口大学大学院創成科学研究科の武宮淳史教授、国立大学法人東京農工大学大学院農学研究院の梅澤泰史教授、同大学大学院生物システム応用科学府博士後期課程(研究当時)の山下昂太氏らを中心とする国際共同研究グループは、植物が乾燥にさらされた際に水分損失を防ぐために行う気孔[1]の閉鎖メカニズムの一端を明らかにしました。 植物の気孔は、光合成に必要な二酸化炭素の取り込みを担うとともに、蒸散[2]を通じて葉面温度を調節する等の重要な役割を果たしています。しかし、乾燥ストレス下では水分損失の抑制が最優先となるため、植物ホルモンであるアブシジン酸(ABA)...
関連分野数物系科学生物学総合理工工学総合生物農学医歯薬学研究キーワード エストニア/質量分析装置/水蒸気/光合成/高等植物/質量分析/生産性/二酸化炭素/モデル生物/カルシウムイオン/プロトプラスト/リン酸/植物ホルモン/変異体/シロイヌナズナ/環境ストレス/カルシウムチャネル/乾燥ストレス/水利用/Ca2+/プロテインキナーゼ/リン酸化プロテオーム/細胞膜/ROS/ホルモン/カルシウム/キナーゼ/ストレス応答/活性酸素/活性酸素種/電気生理学/翻訳後修飾/ストレス/遺伝学/遺伝子/生理学/分子生物学
この記事の詳細を読む
|
![]() この記事は
会員専用です | 複合領域
福井大学
連合教職開発研究科(連合教職大学院)と信濃教育会が連携に関する協定を締結しました
関連分野複合領域研究キーワード 研修プログラム
|
![]() この記事は
会員専用です | 数物系科学
高エネルギー加速器研究機構
【KEKのひと#67】“人間ニュートリノ”として研究者をサポートします!藤 平四郎(とう・へいしろう)さん
関連分野情報学数物系科学工学医歯薬学研究キーワード ゲーム/スーパーカミオカンデ/ニュートリノ振動/ヒッグス/ヒッグス粒子/陽子/J-PARC/素粒子/ニュートリノ/宇宙線/観測装置/素粒子物理/コロナ禍/原子力/スポーツ/コミュニケーション
|
![]() この記事は
会員専用です | 工学
帯広畜産大学
浅利裕伸准教授が第30回「野生生物と社会」学会大会において学会賞を受賞
関連分野工学農学研究キーワード 持続可能/まちづくり/持続可能な開発/哺乳類/森林伐採
|
![]() この記事は
会員専用です | 工学
京都工芸繊維大学
KIT-ASEAN Joint Seminar 2025を開催しました
関連分野工学研究キーワード ベトナム
|
![]() この記事は
会員専用です | 工学
金沢大学
ベトナムのカントー医科薬科大学代表団が角間キャンパスと宝町・鶴間キャンパスを訪問
関連分野工学医歯薬学研究キーワード 持続可能/持続可能な開発/ベトナム/医師
|
![]() この記事は
会員専用です | 工学
京都工芸繊維大学
第15回4大学連携研究フォーラムを開催しました
関連分野工学研究キーワード 情報交換
|
![]() この記事は
会員専用です | 工学
鹿児島大学
第13回稲盛アカデミー公開シンポジウムを開催しました
関連分野生物学工学研究キーワード 公開シンポジウム/持続可能/持続可能な開発
|
| この記事は
会員専用です | 工学
岡山大学
岡山大学シンポジウム「岡山発、森林循環経済の実現に向けて」を開催
関連分野生物学工学研究キーワード 公開シンポジウム/森林資源
|
![]() この記事は
会員専用です | 工学
千葉大学
大学院教育改革フォーラム2025を開催
関連分野複合領域工学研究キーワード 産学連携/キャリア
|
![]() この記事は
会員専用です | 工学
島根大学
令和7年度第三回学長記者会見を開催しました
関連分野工学研究キーワード 材料科学/持続可能/社会貢献
|
![]() この記事は
会員専用です | 工学
金沢大学
雑談のチカラ「金沢を代表する陶芸家,大樋年雄さんと語る!」を実施
関連分野工学研究キーワード キャリア/持続可能/持続可能な開発
|
![]() この記事は
会員専用です | 工学
金沢大学
博士研究人材支援・研究力強化戦略プロジェクト(HaKaSe⁺)令和8年度4月期募集開始
関連分野工学“Kanazawa University Strategic Project for Development of Doctoral Students and Research Promotion (HaKaSe⁺) ” is now accepting applications for April 2026 研究キーワード 持続可能/持続可能な開発
|
![]() この記事は
会員専用です | 工学
東京科学大学
新規窒化物強誘電体薄膜を用いた積層キャパシタの大幅なスケールダウンに成功
ロジック混載型次世代強誘電体メモリの実用化を加速
研究キーワード プロセッサ/低消費電力化/モノのインターネット(IoT)/最適化/電気分極/誘電性/エントロピー/スケーリング/高周波/圧電性/トンネル電流/強誘電性/電極界面/材料プロセス/ZnO/キャパシタ/ゲート絶縁膜/データストレージ/トランジスタ/メモリ/メモリ素子/圧電デバイス/圧電効果/強誘電体薄膜/高電圧/酸化亜鉛/絶縁体/双極子/半導体デバイス/誘電体/誘電特性/圧電体/強誘電体/酸化ハフニウム/単結晶/窒化物/不揮発性メモリ/MEMS/アルミニウム/センサー/トンネル/ナノサイズ/ナノスケール/高効率化/集積回路/新エネルギー/積層構造/耐久性/窒化アルミニウム/低消費電力/熱処理/半導体/機能性/結晶構造/結晶性/層構造/構造変化
|
![]() この記事は
会員専用です | 工学
東京科学大学
均一サイズの生体分子凝集体の生成・集積制御を実現
マイクロチップの振動により「微小渦群」を発生させDNAナノ構造の凝集体形成制御に応用
研究キーワード 自律システム/分子ロボット/閉じ込め/相分離/分子構造/高分子/塩基配列/走査型電子顕微鏡/プロセッシング/ナノ構造体/位置制御/蛍光観察/ボトムアップ/PDMS/トラップ/ナノ構造/マイクロ/マイクロ流路/ロボット/圧電素子/構造制御/周波数/電子顕微鏡/流体制御/流体力/流体力学/人工細胞/細胞凝集/SEM/細胞モデル/機能性/酵素反応/染色体/組織化/ナノテクノロジー/in vitro/バイオテクノロジー/マイクロチップ/ラット/凝集体/合成生物学/生体高分子/生体分子/分子認識/脂質/生体材料
|
![]() この記事は
会員専用です | 工学
東京科学大学
高次構造の制御により優れた抗血栓性を発現する固体状ポリマーコーティング材料を開発
高分子の高次構造制御が拓く新たな材料設計指針
研究キーワード インターフェース/医療機器/化学物質/強い相互作用/弱い相互作用/水分子/水和構造/ガラス転移/分子構造/コンホメーション/構造形成/フィルム/液晶/高次構造制御/高分子/立体規則性/ファイバー/走査型電子顕微鏡/ガラス転移温度/フレキシブル/アモルファス/ナノファイバー/材料設計/コーティング/ポリマー/構造制御/長寿命化/電子顕微鏡/導電性/バイオインターフェース/機能性/血栓/ステント/抗菌性/合併症/分子機能/寿命/規則構造/血液/血小板/高次構造/細胞接着
|
| この記事は
会員専用です | 農学
室蘭工業大学
泉 佑太准教授が北海道科学技術奨励賞を受賞しました
関連分野工学農学研究キーワード センシング/土砂災害
|
![]() この記事は
会員専用です | 農学
島根大学
堀之内准教授らの造成海草藻場魚類群集に関する論文が国際学術誌Ichthyological Researchの編集長推薦論文に選出されました【エスチュアリー研究センター】
関連分野複合領域環境学工学農学研究キーワード 持続性/沿岸生態系/海草藻場/持続可能/沿岸環境/持続可能な開発/沿岸域/生態系/群集構造/漁業/生態学/生物多様性
|
| この記事は
会員専用です | 医歯薬学
東京大学
“治療抵抗性”とされてきたBRCA野生型卵巣がんに 有効な治療標的を発見
―PLK1/WEE1阻害によりDNA修復の弱点を狙い撃ち―
研究キーワード 抵抗性/DNA修復/治療抵抗性/治療標的/卵巣/卵巣がん/DNA損傷/マウス/抗腫瘍効果/細胞死/細胞周期/バイオマーカー
|
![]() この記事は
会員専用です | 医歯薬学
横浜国立大学
ボッシュ・レックスロス株式会社様に感謝状を贈呈しました
関連分野工学医歯薬学研究キーワード キャリア/トレーニング
|
![]() この記事は
会員専用です | 医歯薬学
鹿児島大学
「最新の感染症研究とコホート研究プラットフォーム」についてLINK-Jで発表しました
関連分野工学農学医歯薬学研究キーワード スピルオーバー/持続可能/持続可能な開発/獣医学/ウイルス感染症/運動機能/心臓/新型コロナウイルス/歯学/ラット/血液/抗ウイルス薬/心電図/ウイルス/コホート/ヘルスケア/ワクチン/介護予防/感染症/血圧/高血圧/高齢化/新型コロナウイルス感染症/早期発見/多職種連携/認知機能/認知症
|
| この記事は
会員専用です | 医歯薬学
島根大学
SAN´INダイバーシティ推進ネットワーク年次報告書(令和6年度)及びNewsLetter vol.12を発行しました
関連分野医歯薬学研究キーワード ダイバーシティ
|
| この記事は
会員専用です | 医歯薬学
岡山大学
OU-SPRING・BOOST Winter Research Symposium 2025を開催
関連分野情報学複合領域農学医歯薬学研究キーワード 人工知能(AI)/プレゼンテーション/人的ネットワーク/腎臓病/糸球体/スキル/ファージ/マクロファージ/腎臓/コミュニケーション/コミュニティ/異分野融合/慢性腎臓病
|
| この記事は
会員専用です | 医歯薬学
信州大学
田口 精一 教授(特定雇用)が『日本農芸化学会賞』を受賞しました
関連分野化学工学総合生物農学医歯薬学研究キーワード 環境調和/持続可能/物質生産/バイオマテリアル/微生物代謝/微生物/バイオテクノロジー/生理学
|
![]() この記事は
会員専用です | 医歯薬学
室蘭工業大学
第31回室蘭工業大学学長杯争奪ロボットサッカーコンテストを開催します
関連分野工学医歯薬学研究キーワード ロボット/サッカー
|
![]() この記事は
会員専用です | 医歯薬学
東北大学
植物の永続的な成長を支える分子機構を解明
~成長点の司令塔を担う転写因子が鍵~
研究キーワード オーガナイザー/コケ植物/ゼニゴケ/器官形成/持続可能/持続可能な開発/遺伝子改変/オーキシン/植物ホルモン/環境応答/生合成/生合成酵素/自己複製/ホルモン/ゆらぎ/分子機構/インドール/遺伝子発現制御/幹細胞/細胞分裂/転写因子/発現制御/ゲノム/遺伝子/遺伝子発現
|
![]() この記事は
会員専用です | 医歯薬学
室蘭工業大学
GOOD ACTION シェアリング2025を開催しました
関連分野情報学医歯薬学研究キーワード エージェント/モチベーション/働き方改革
|
| この記事は
会員専用です | 医歯薬学
島根大学
ミリスチン酸のヒト食後血糖値上昇に対する抑制効果を初実証【総合科学研究支援センター・堺助教】
研究キーワード 脂肪酸/臨床試験
|
![]() この記事は
会員専用です | 医歯薬学
群馬大学
イヌを飼育する児童の幸福度の上昇には細菌叢の変化が関与
関連分野複合領域数物系科学工学農学医歯薬学研究キーワード 心身の健康/閉じ込め/システム制御/変異体/獣医学/無菌マウス/思春期/マウス/コホート/育児/細菌/細菌叢/腸内細菌/腸内細菌叢
|
![]() この記事は
会員専用です | 医歯薬学
名古屋大学
音の方向感知はオリゴデンドロサイトの多様性に支えられている
関連分野情報学生物学工学総合生物医歯薬学研究キーワード 音源定位/ナトリウムチャネル/3次元構造/マイクロ/神経活動/ナトリウム/ニワトリ/髄鞘/グリア細胞/聴覚/グリア/神経回路/生理学
|
| この記事は
会員専用です | その他
島根大学
島根大学×閩南師範大学オンライン交流イベントを開催しました。
|
![]() この記事は
会員専用です | その他
室蘭工業大学
THE学際科学ランキング2026に道内の大学で唯一ランクインしました
|